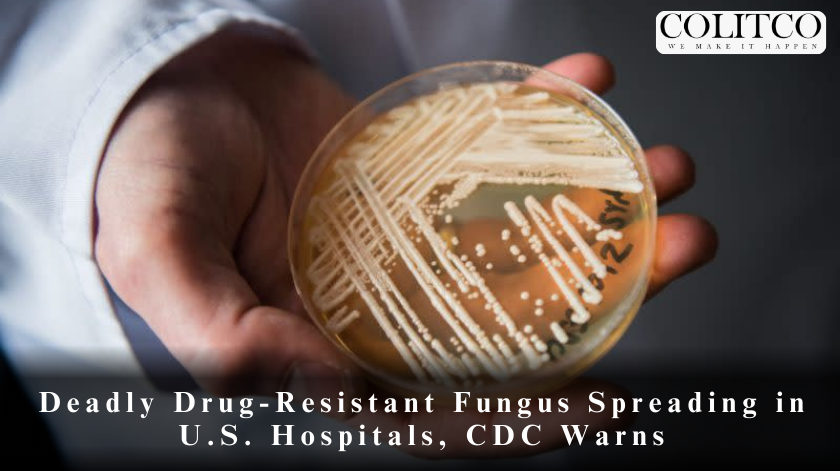
Deadly Drug-Resistant Fungs Spreading in US Hospital

A highly dangerous, drug-resistant fungus known as Candida auris is rapidly spreading through healthcare facilities across the United States, raising serious concerns among health officials. The Centers for Disease Control and Prevention (CDC) has classified this fungal infection as an “urgent threat” due to its increasing prevalence, high mortality rate, and resistance to antifungal medications.
Rapid Rise in Cases
Since its first detection in the U.S. in 2016, Candida auris cases have been surging. The latest CDC data reveals that reported infections more than doubled in recent years, with 4,514 cases recorded in 2023 alone. California leads the nation with 1,566 infections, making it the hardest-hit state.
The fungus primarily spreads in hospitals and long-term care facilities, targeting patients with weakened immune systems. Individuals who have prolonged hospital stays, use medical devices such as ventilators or catheters, or receive broad-spectrum antibiotics are particularly vulnerable.
A Growing Public Health Threat
CDC epidemiologist Dr. Meghan Lyman emphasized the urgency of controlling the outbreak. “The rapid rise and geographic spread of cases is concerning and underscores the need for continued surveillance, expanded lab capacity, and adherence to infection prevention measures,” she stated.
Unlike common fungal infections, Candida auris poses a unique challenge due to its resistance to multiple antifungal drugs. In many cases, it does not respond to standard treatments, making infections difficult to manage and increasing the risk of severe complications or death.
How Candida auris Spreads
The fungus is highly transmissible in healthcare settings, spreading through contaminated surfaces and direct contact. It can persist on medical equipment, hospital furniture, and even patients’ skin, making it difficult to eliminate once it takes hold in a facility.
Infected individuals often do not exhibit symptoms right away, allowing the fungus to spread unnoticed. Once it enters the bloodstream, however, it can cause life-threatening infections, particularly in critically ill patients. Studies suggest that the mortality rate for Candida auris infections can exceed 30%.
Challenges in Detection and Treatment
One of the biggest concerns surrounding Candida auris is its ability to evade detection. Unlike other fungal infections, it is not easily identified through standard laboratory tests, leading to delayed diagnoses.
Furthermore, many strains of the fungus have developed resistance to commonly used antifungal drugs, such as fluconazole. In some cases, even last-resort treatments like echinocandins are ineffective, leaving doctors with limited options.
Health experts warn that without rapid identification and containment, Candida auris could become even more widespread. “Hospitals must prioritize strict infection control measures, including rigorous hand hygiene and environmental disinfection, to prevent further outbreaks,” said Dr. Tom Chiller, head of the CDC’s fungal diseases branch.
Efforts to Contain the Spread
Healthcare facilities are ramping up efforts to curb the spread of Candida auris. Many hospitals are implementing enhanced screening procedures, isolating infected patients, and reinforcing cleaning protocols.
The CDC is also urging state health departments to strengthen their surveillance systems and improve laboratory testing capabilities. Early detection is crucial in preventing the fungus from spreading within healthcare environments.
Additionally, researchers are working to develop new antifungal treatments. Some experimental drugs are showing promise in laboratory settings, but it may take years before they become widely available.
What Patients Can Do
While Candida auris mainly affects hospitalized patients, individuals can take steps to reduce their risk. The CDC advises those with underlying health conditions to maintain proper hygiene, avoid unnecessary antibiotic use, and ensure that healthcare providers follow strict infection control protocols.
Family members of hospitalized patients should also remain vigilant, asking hospital staff about infection prevention measures and ensuring that medical equipment is properly sanitized.
Looking Ahead
As Candida auris continues to spread, health officials stress the importance of proactive measures. The fungus represents a growing threat that could have severe consequences if not contained.
With increased awareness, improved detection, and enhanced hospital protocols, experts hope to slow its transmission and protect vulnerable populations. However, they warn that without immediate action, Candida auris could become an even more significant public health crisis in the years to come.